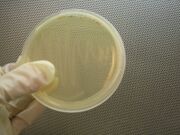

Uploads by Beanderpa
From OpenWetWare
Jump to navigationJump to search
This special page shows all uploaded files.
| Date | Name | Thumbnail | Size | Description |
|---|---|---|---|---|
| 05:33, 27 October 2006 | Streaked plate.jpg (file) | |
390 KB | |
| 05:29, 27 October 2006 | Falcon tube.jpg (file) |  |
422 KB | |
| 05:25, 27 October 2006 | Inoculation.jpg (file) |  |
389 KB | |
| 05:18, 27 October 2006 | Colony selection.JPG (file) |  |
378 KB | |
| 05:10, 27 October 2006 | Colony selection.jpg (file) |  |
378 KB | |
| 00:43, 27 October 2006 | Doubledigesttable.JPG (file) |  |
83 KB |